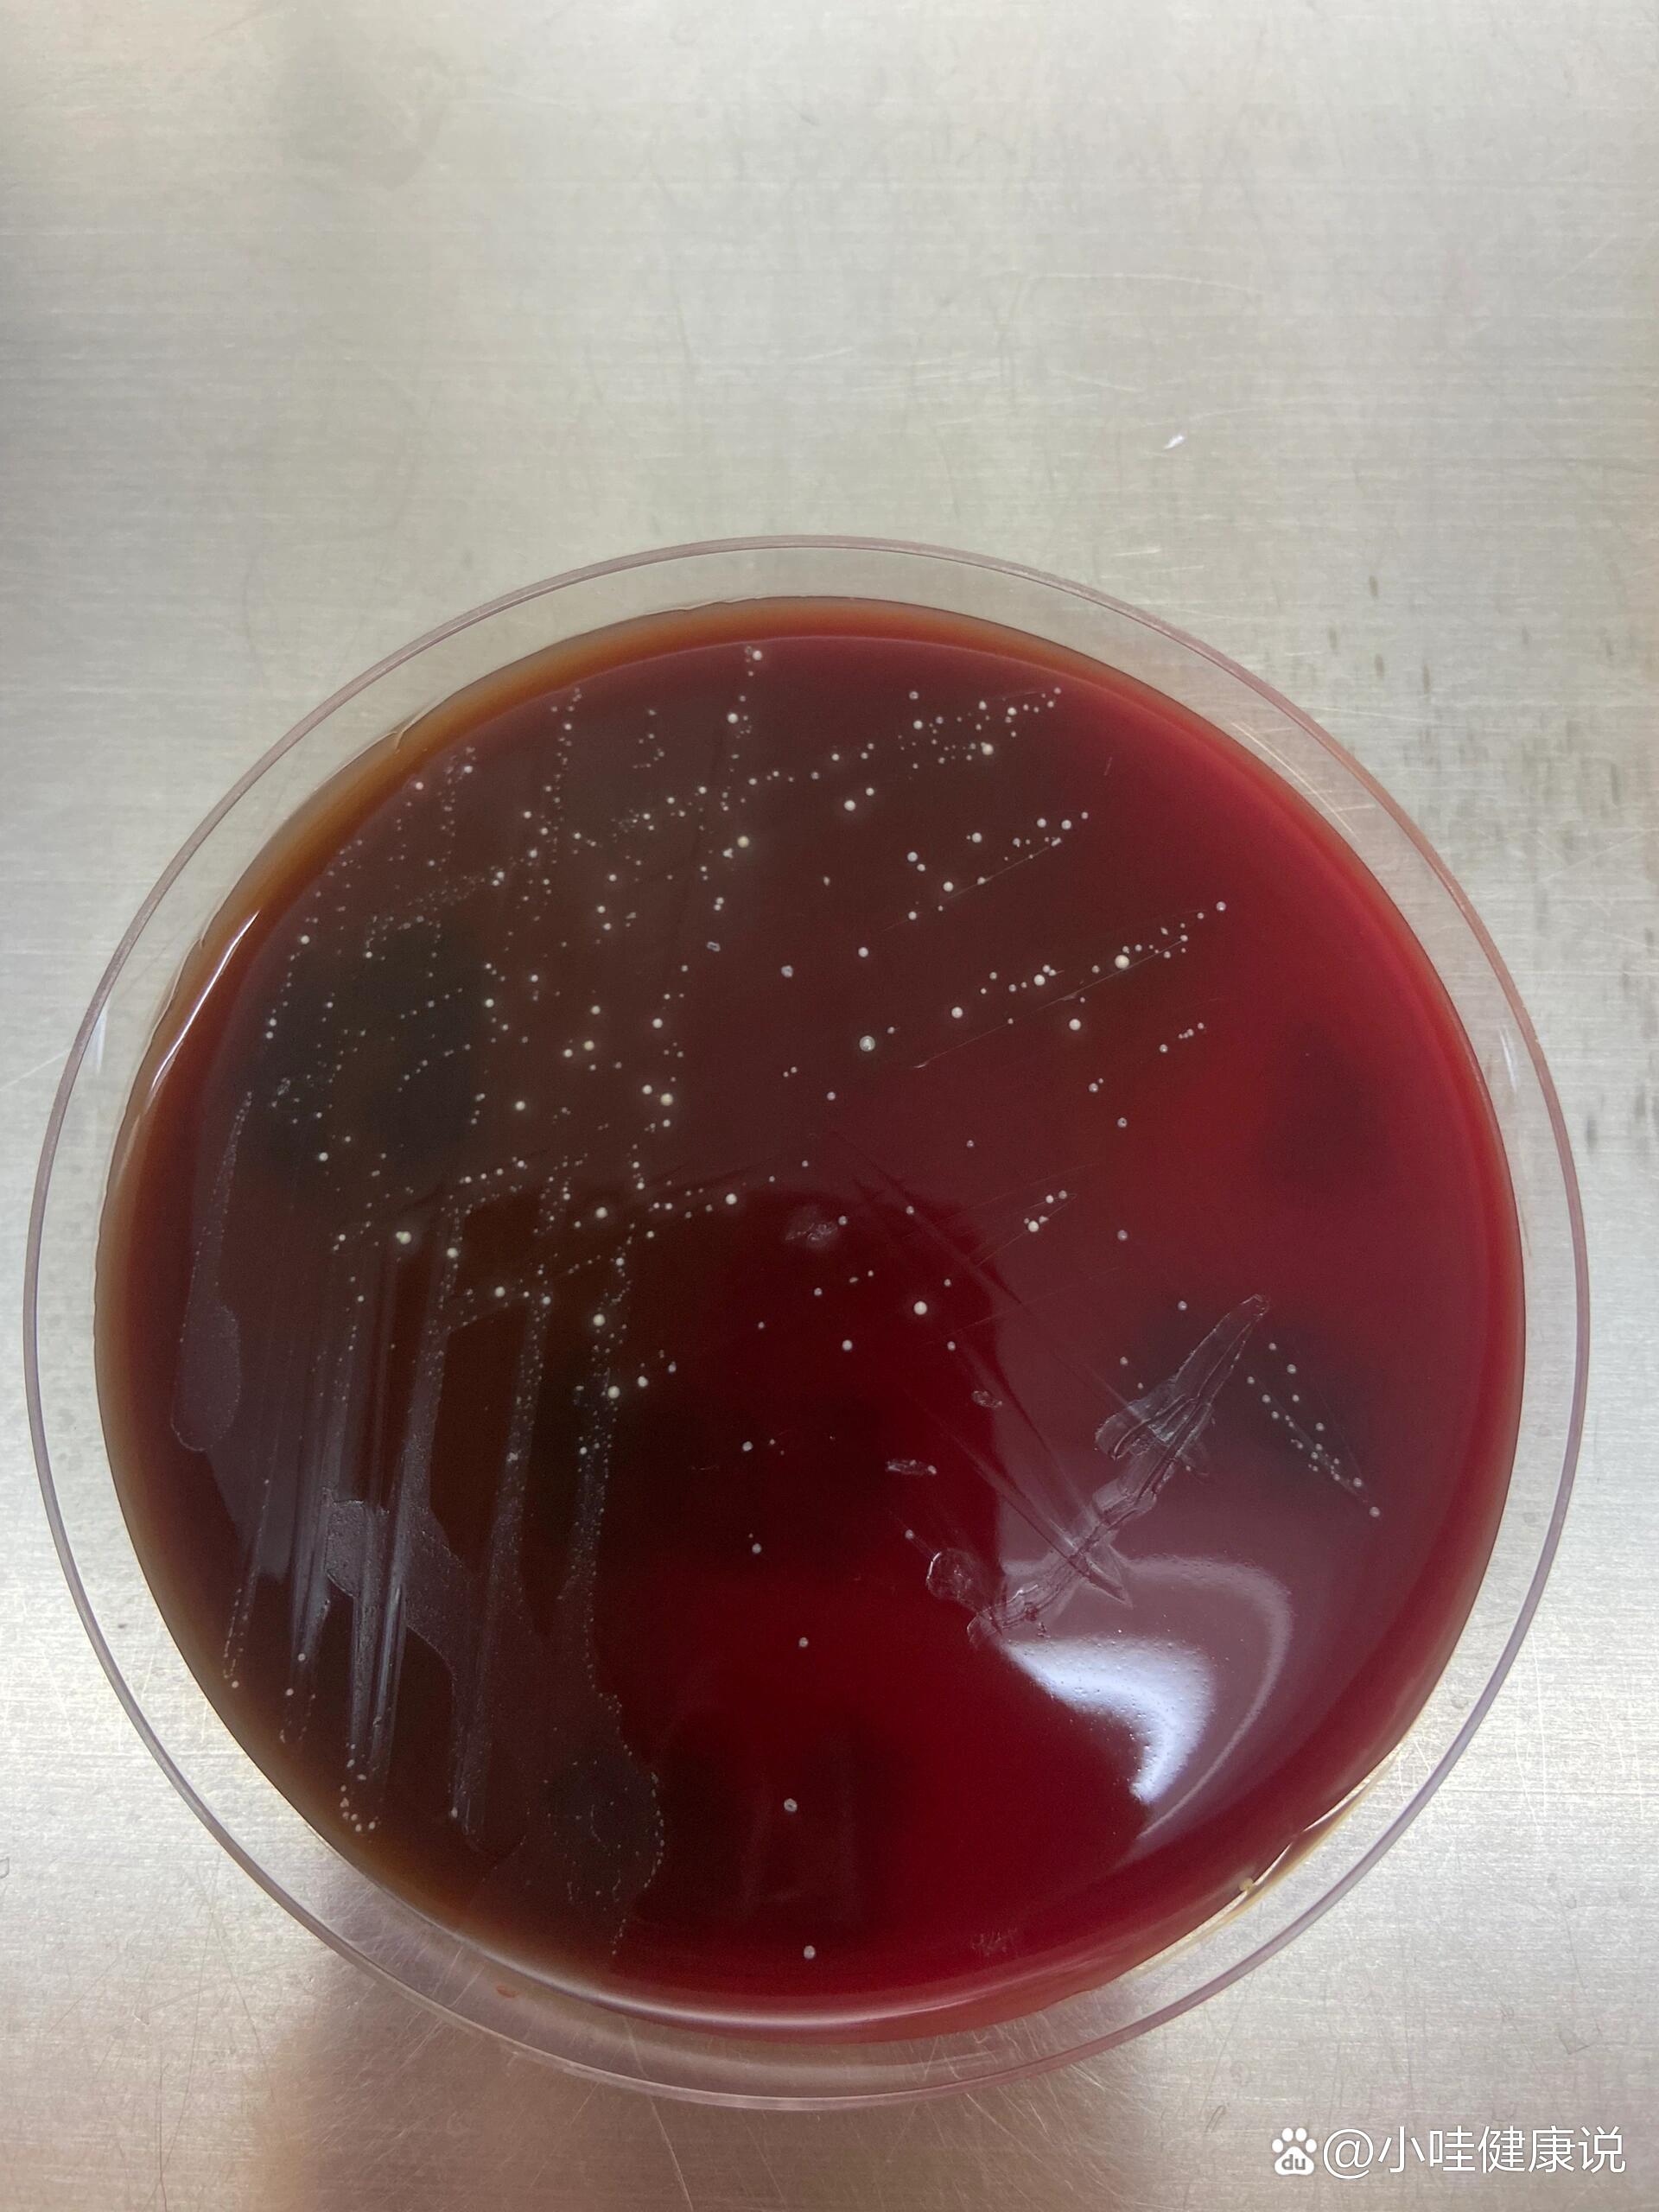
化脓链球菌

化脓性链球菌图片

化脓性链球菌 革兰阳性球菌,单个,成双或链状排列,菌落较小,有β溶血
图片尺寸1280x1280
化脓性链球菌 革兰阳性球菌,单个,成双或链状排列,菌落较小,有β溶血
图片尺寸1280x1280
化脓性链球菌 革兰阳性球菌,单个,成双或链状排列,菌落较小,有β溶血
图片尺寸1280x1280
化脓链球菌
图片尺寸1920x2560
对小朋友伤害很大的细菌~化脓链球菌( a群链球菌) - 抖音
图片尺寸1080x815
化脓性链球菌 化脓性链球菌
图片尺寸1920x1808
化脓性链球菌图片_化脓性链球菌高清图片素材库
图片尺寸800x533酿脓链球菌
图片尺寸1200x675
化脓性链球菌图片_化脓性链球菌高清图片素材库
图片尺寸800x600
化脓性链球菌 (其他生物相关)
图片尺寸1200x900
左下肢化脓性链球菌感染
图片尺寸2976x2976
化脓链球菌
图片尺寸1920x2560
streptococcus pyogenes 化脓性链球菌 - gram positive, non-motile
图片尺寸1440x1920
左下肢化脓性链球菌感染
图片尺寸2976x2976data-id="gncocem3km">链球菌是 a target="_blank" href="/item/化脓
图片尺寸1280x1182
化脓性链球菌复发感染如何影响大脑功能
图片尺寸400x245
化脓性链球菌,一种潜在的致命细菌
图片尺寸800x765streptococcuspyogenes化脓性链球菌
图片尺寸1080x1440
化脓链球菌.(图片来源:《朝日新闻》网站)
图片尺寸640x480
左下肢化脓性链球菌感染
图片尺寸2976x2976
猜你喜欢:猪化脓性链球菌图片化脓性链球菌化脓性链球菌感染链球菌图片链球菌图片手绘图肺炎链球菌图片链球菌感染图片化脓性皮炎图片化脓性球菌急性化脓性阑尾炎图片化脓性毛囊炎图片化脓性肉芽肿图片化脓性咽炎图片化脓性皮肤病图片化脓性汗腺炎图片化脓性腱鞘炎图片化脓性咽峡炎图片化脓性阑尾炎图片链球菌显微镜下图片猪败血性链球菌病猪链球菌病的症状图片化脓性指头炎初期图片化脓性肉芽肿初期图片化脓性汗腺炎初期图片口腔化脓性肉芽肿图片肛周化脓性汗腺炎图片链球菌手绘图溶血性链球菌化脓性阑尾炎切片肺炎链球菌荚膜手绘图图底关系分析红砖瓦房图片小火盖精致手绘古装美人图铜牛鼻环全部图片可爱的英文字体超好看的闺蜜头像图片骑行美照sky光遇面具中国标志有哪些我是多余的人图片伤感touch清秋女装